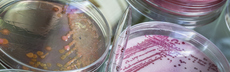
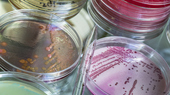

Neue Methoden ermöglichen bessere Sepsis-Therapie
Sie kann durch Bakterien, aber auch durch Viren
oder Pilze ausgelöst werden.
Eine Sepsis verläuft oft tödlich. Und auch nach einer erfolgreichen Behandlung können Spätschäden wie chronische Erschöpfung oder Schmerzen bleiben.
Herkömmliche Verfahren benötigen aber bis zu einen Tag, um zu einem Ergebnis zu kommen.
"Die Herausforderung ist, die oft nur ein millionstel Meter kleinen bakteriellen Erreger direkt aus den komplexen Proben der Patientinnen und Patienten im Laserfokus zu fangen und zu charakterisieren."
Prof. Dr. Ute Neugebauer, Leiterin der Core Unit Biophotonik und der Forschungsabteilung Klinisch-Spektroskopische Diagnostik am Leibniz-IPHT.
So könnte der Schnelltest in Zukunft auch Patientinnen und Patienten an Orten, an denen keine Klinik oder ein Speziallabor in der Nähe ist, zu einer genaueren Behandlung verhelfen.
Das Verfahren wird nun im Leibniz-Zentrum für Photonik in der Infektionsforschung (LPI Jena) weiterentwickelt und soll in eine breite Anwendung gebracht werden.
- Artikel "Neues Testverfahren ermöglicht eine gezieltere Sepsis-Behandlung" im Newsletter 101 des BMBF
- Der Comic "Lasergirl - Jagd auf den Killerkeim" wurde aus dem Preisgeld des vom BMBF 2019 erstmals verliehenen Ralf-Dahrendorf-Preises entwickelt

Neue Methoden ermöglichen bessere Sepsis-Therapie
Neue Methoden ermöglichen bessere Sepsis-Therapie












